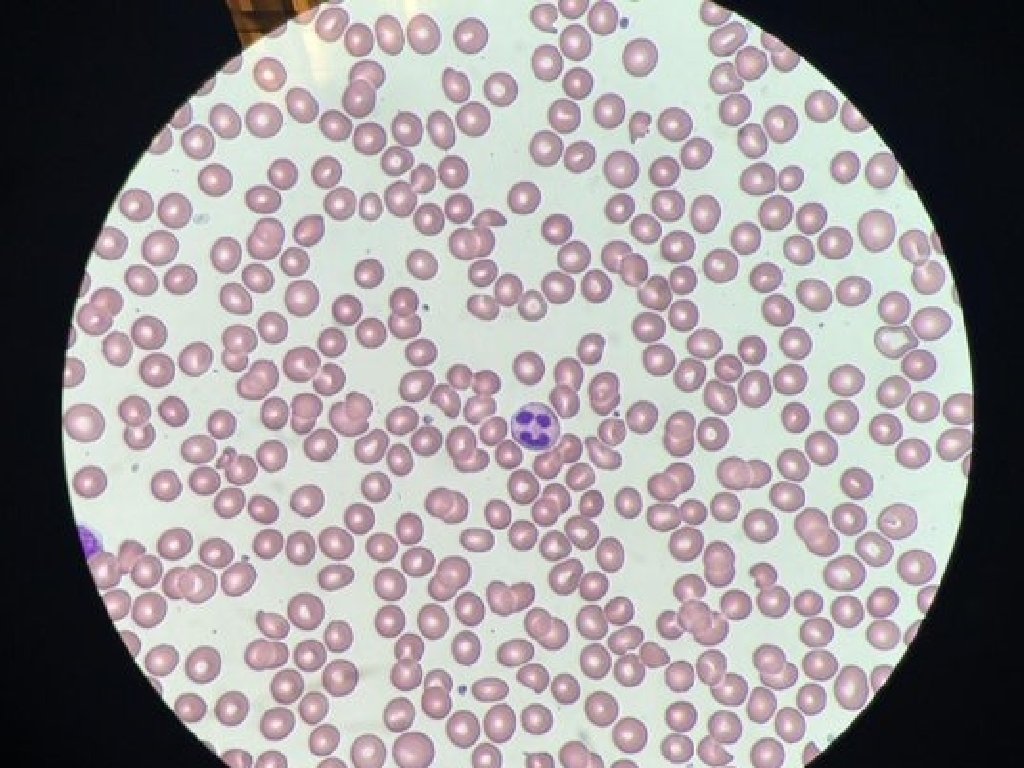

XI Jornada informativa para futuros mdico internos residentes



















- Slides: 19

XI Jornada informativa para futuros médico internos residentes Hospital Universitario Río Hortega y Gerencia de Atención Primaria de Valladolid Oeste Servicio de Hematología y Hemoterapia

XI Jornada informativa para futuros médico internos residentes Hospital Universitario Río Hortega y Gerencia de Atención Primaria de Valladolid Oeste Servicio de Hematología y Hemoterapia Programa formativo Primer año Especialidades médicas Rotación externa. Segundo año Hematología clínica - planta de Hospitalización y Unidad de trasplante de progenitores hematopoyéticos. Tercer año Citología, eritropatología y citometría Rotación externa. Cuarto año Hemostasia y trombobosis. Medicina transfusional e inmunohematología

XI Jornada informativa para futuros médico internos residentes Hospital Universitario Río Hortega y Gerencia de Atención Primaria de Valladolid Oeste Servicio de Hematología y Hemoterapia Programa formativo. Primer año de residencia 2 meses Neumología - guardias de Medicina Interna. 2 meses Cardiología - guardias de Cardiología. 2 meses Medicina interna - guardias de Medicina Interna. 1 mes Pediatría - sin guardias. 3 meses Rotación externa - Microbiología clínica H. U. Gregorio Marañón - guardias de microbiología 1 mes Medicina Intensiva- guardias de UCI 2 guardias/mes en el Sº de Urgencias.

XI Jornada informativa para futuros médico internos residentes Hospital Universitario Río Hortega y Gerencia de Atención Primaria de Valladolid Oeste Servicio de Hematología y Hemoterapia Segundo año de residencia: Clínica hematológica • • • Planta de hospitalización. Unidad de trasplante de PH (T. A. M. O. ) Pediatría.

XI Jornada informativa para futuros médico internos residentes Hospital Universitario Río Hortega y Gerencia de Atención Primaria de Valladolid Oeste Servicio de Hematología y Hemoterapia Auto-TPH Alo-TPH DE Haplo-TPH Alo-TPH DNE

XI Jornada informativa para futuros médico internos residentes Hospital Universitario Río Hortega y Gerencia de Atención Primaria de Valladolid Oeste Servicio de Hematología y Hemoterapia Tercer año de residencia. Citología, eritropatología y citometría.

XI Jornada informativa para futuros médico internos residentes Hospital Universitario Río Hortega y Gerencia de Atención Primaria de Valladolid Oeste Servicio de Hematología y Hemoterapia

XI Jornada informativa para futuros médico internos residentes Hospital Universitario Río Hortega y Gerencia de Atención Primaria de Valladolid Oeste Servicio de Hematología y Hemoterapia

XI Jornada informativa para futuros médico internos residentes Hospital Universitario Río Hortega y Gerencia de Atención Primaria de Valladolid Oeste Servicio de Hematología y Hemoterapia Ser Ser

XI Jornada informativa para futuros médico internos residentes Hospital Universitario Río Hortega y Gerencia de Atención Primaria de Valladolid Oeste Servicio de Hematología y Hemoterapia Ser Ser

XI Jornada informativa para futuros médico internos residentes Hospital Universitario Río Hortega y Gerencia de Atención Primaria de Valladolid Oeste Servicio de Hematología y Hemoterapia Ser Ser

XI Jornada informativa para futuros médico internos residentes Hospital Universitario Río Hortega y Gerencia de Atención Primaria de Valladolid Oeste Servicio de Hematología y Hemoterapia Ser Ser

XI Jornada informativa para futuros médico internos residentes Hospital Universitario Río Hortega y Gerencia de Atención Primaria de Valladolid Oeste Servicio de Hematología y Hemoterapia Ser Ser

XI Jornada informativa para futuros médico internos residentes Hospital Universitario Río Hortega y Gerencia de Atención Primaria de Valladolid Oeste Servicio de Hematología y Hemoterapia Cuarto año de residencia Medicina Transfusional e Inmunohematología. Hemostasia y trombosis. Centro de Hemodonación de Castilla y León (CHEMCYL). Consulta (general) del residente.

XI Jornada informativa para futuros médico internos residentes Hospital Universitario Río Hortega y Gerencia de Atención Primaria de Valladolid Oeste Servicio de Hematología y Hemoterapia Guardias • • Número permitido: cuatro Guardias de especialidad: sí, a partir del segundo año. • • Adjunto presencial Libranza: sí (durante el primer año guardias: 2 en Urgencias y 2 en el servicio en el se esté rotando).

XI Jornada informativa para futuros médico internos residentes Hospital Universitario Río Hortega y Gerencia de Atención Primaria de Valladolid Oeste Servicio de Hematología y Hemoterapia Rotaciones externas • • Primer año de residencia - servicio de Microbiología Clínica de H. U. Gregorio Marañón Tercer año de residencia - trasplante alogénico de donante no emparentado.

XI Jornada informativa para futuros médico internos residentes Hospital Universitario Río Hortega y Gerencia de Atención Primaria de Valladolid Oeste Servicio de Hematología y Hemoterapia Asistencia a cursos, seminarios y congresos • • • Sesiones clínicas miércoles Sesiones bibliográficas jueves Congreso regional Congreso nacional Cursos y seminarios